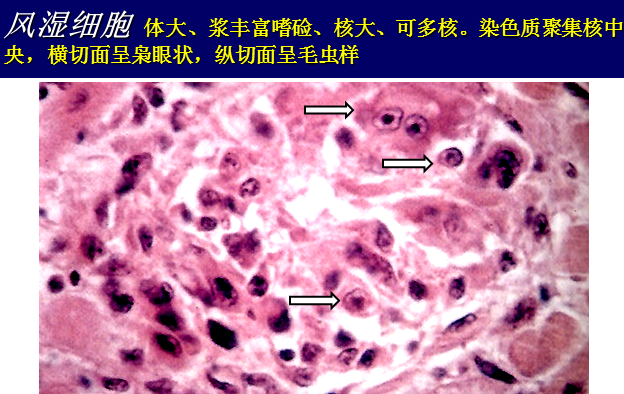

教学课件
教学重点(尤其注意红色字体)
风湿病(rheumatism)是一种与咽喉部A组乙型溶血性链球菌感染有关的变态反应性炎性疾病。主要侵犯全身结缔组织,以胶原纤维的纤维素样坏死和风湿小体形成为病理特征。最常累及心脏、关节,其次为皮肤、皮下组织、脑和血管,其中以心脏病变最为严重。常反复发作,急性期称为风湿热(rheumatic fever)。临床除有心脏和关节症状外,常伴有发热、皮疹、皮下结节、血沉加快、抗链球菌溶血素抗体(抗“O”)滴度增高等表现。
本病为一种常见病,在我国各地均有发生,但地区差异较大:四川、浙江、湖北较高,广东最低,这与即往的调查相反。风湿病可发生于任何年龄,但多始发于5~15岁之间,发病高峰为6~9岁。年发病率20.05/10万。由于本病常反复发作,可造成心瓣膜的器质性损伤,形成风湿性心瓣膜病。
一、病因及发病机制
抗原抗体交叉反应学说:链球菌细胞壁的C抗原、M抗原的抗体分别与结缔组织和心肌、血管平滑肌起交叉反应。

二、基本病理变化
风湿病的基本病变是胶原纤维的纤维素样坏死和风湿小体的形成。
病变发展大致分为变质渗出期、增生期和瘢痕期三期。
1、变质渗出期

2、增生期或肉芽肿期
在纤维素样坏死的周围出现Aschoff细胞,并增生形成风湿小体或Aschoff 小体。
Aschoff 小体镜下呈圆形或梭形,常位于心肌间质小血管旁,亦见于心内膜、心外膜、关节、皮下结缔组织以及血管等处。
Aschoff细胞胞浆丰富,略带嗜碱性,核大呈空泡状,圆形或长圆形,染色质集于中央,在核的横肉切面形似枭眼,纵切面形似毛虫状,可有双核或多核。

3、瘢痕期
随着纤维素样坏死物渐渐被吸收,Aschoff细胞转变为纤维母细胞,产生胶原纤维,使原来的风湿小体逐渐纤维化,最终整个小体变成梭形微小的疤痕。此期约经过2~3个月。
三、风湿病的各个器官病变
1.风湿性心脏病
风湿性心脏病(rheumatic heart disease,RHD)包括急性期的心脏炎和静止期的慢性风湿性心脏病(主要是心瓣膜病)。
风湿性心脏炎(rheumatic carditis)或风湿性全心炎,包括风湿性心内膜炎、风湿性心肌炎和风湿性心外膜炎即心包炎。
(1)风湿性心内膜炎:主要侵犯心瓣膜,以二尖瓣最多见,其次为二尖瓣和主动脉瓣同时受累。急性期:瓣膜闭锁缘疣状赘生物(白色血栓)形成,直径1-3mm,灰白色,串珠状,不易脱落。镜下,为血小板和纤维素构成的白色血栓。病变后期,赘生物发生机化,导致瓣膜增厚、变硬、卷曲、缩短,瓣叶间相互粘连,腱索增粗、缩短,最终导致瓣膜病(瓣膜口狭窄和关闭不全),造成全身血液循环障碍。




(2)风湿性心肌炎:以间质内小血管旁出现风湿性小体为特征。
(3)风湿性心外膜炎:病变主要累及心包脏层,呈浆液性或浆液纤维素性炎,偶有风湿小体。当以大量纤维素渗出为主时,覆盖在心外膜表面的纤维素可因心脏搏动牵拉而成绒毛状,称为绒毛心(干性心包炎)。当以浆液渗出为主时,形成心包炎性积液(湿性心包炎)。以后风湿病变消退,浆液和纤维素如不能完全溶解吸收,可发生机化,使心包脏层和壁层发生局部粘连,甚至形成缩窄性心包炎(constrictive pericarditis)。


2.风湿性关节炎:侵犯大关节,如膝、踝、肩、腕、肘、髋关节。游走性、反复发作。浆液性炎,不遗留关节变形。
3.皮肤病变:环形红斑、皮下结节。
4.风湿性动脉炎:大小动脉均可受累,尤其小动脉。管壁纤维素样坏死或风湿小体形成,淋巴细胞、单核细胞浸润。
5.风湿性脑病:小舞蹈症。

